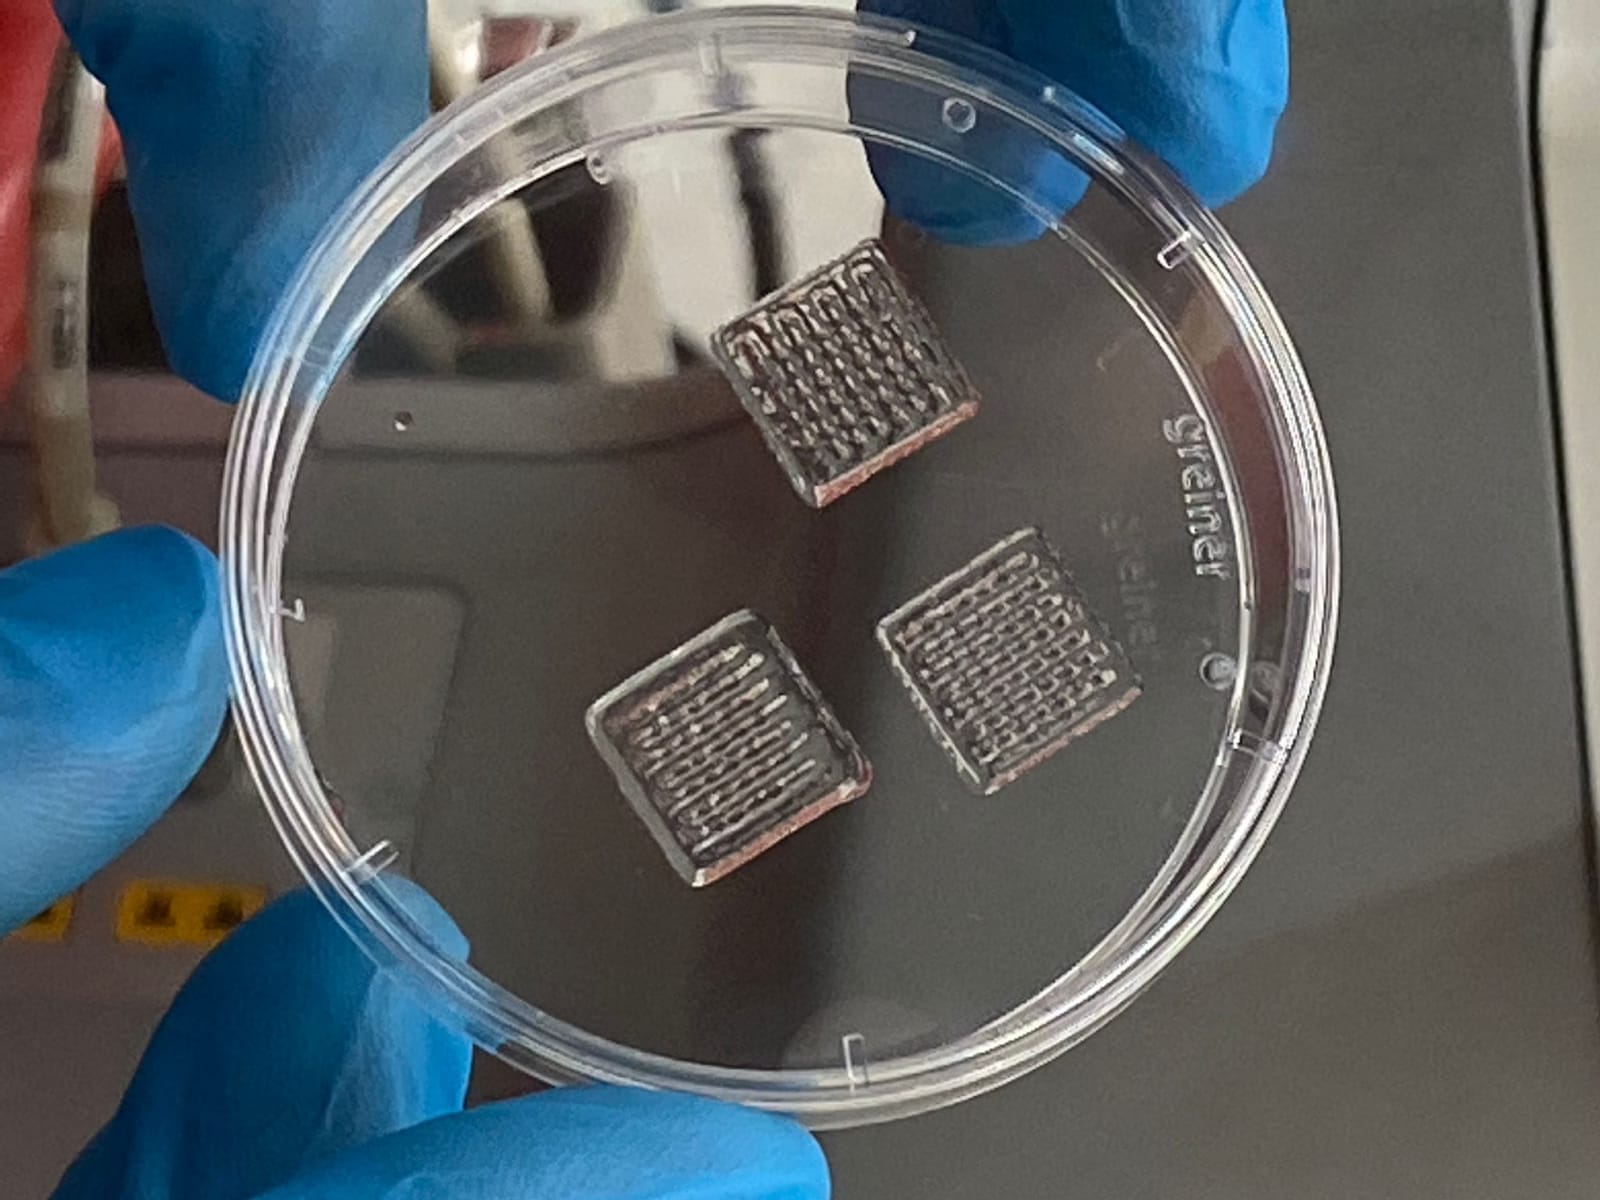

Investigadores andaluces desarrollarán una retina artificial para estudiar la degeneración macular juvenil
Investigadores de la Fundación Progreso y Salud, entidad perteneciente a la Consejería de Salud y Consumo, se encuentran desarrollando una retina artificial para estudiar en detalle la enfermedad de Stargardt, una patología que causa pérdida de visión central.
El proyecto, liderado por el científico Álvaro Plaza Reyes y Berta de la Cerda Haynes -que desarrollan su trabajo en Laboratorio de Degeneración de la Retina de CABIMER-, pretende construir un modelo de retina utilizando células pluripotentes humanas y empleando metodologías de bioimpresión 3D y edición genómica de última generación. Este prototipo de retina artificial servirá como modelo preclínico y toxicológico sobre el que desarrollar estudios de fármacos y terapias dirigidas y, además, “nos permitirá conocer más a fondo fenómenos complejos como el rechazo inmunitario del trasplante”, explica Plaza.
Este modelo artificial presentará aspectos funcionales y estructurales clave de la retina, por lo que tiene “un enorme potencial y supone un verdadero avance científico, en el desarrollo de modelos de órganos que permitirán tratar mejor las enfermedades que le afectan”, asegura el científico.
La enfermedad de Stargardt es una forma hereditaria de degeneración macular que causa pérdida de la visión central; a veces se denomina degeneración macular juvenil o de aparición temprana. Con frecuencia se diagnostica en la niñez o en la adolescencia y actualmente no existe un tratamiento eficaz, “entre otras razones, porque no existe un modelo artificial en el que ensayar diversos tratamientos para curar esta enfermedad”, explica Reyes.
Este proyecto de investigación se enmarca en un consorcio integrado por diferentes investigadores europeos y ha obtenido más de 93.000 euros de financiación en la convocatoria competitiva de Ayudas a la Investigación Biomédica y en Ciencias de la Salud de la Consejería de Salud y Consumo. Además, cuenta con la participación de profesionales del Hospital Universitario Virgen Macarena de Sevilla; la Universidad de Módena; el laboratorio Tecnopolo Mario Veronesi de Mirandola (Italia); la empresa sueca Cellink, de bioimpresión; y la asociación Mácula Retina de familiares y pacientes con enfermedades de la retina.
Desde sus comienzos, la investigación de Plaza se ha centrado en la terapia celular de las enfermedades de la retina. Su trabajo se suma al del resto de investigadores que forman parte del grupo ‘Degeneración retinal: de la genética a la terapia’, liderado por el investigador Francisco Díaz Corrales, también de la Fundación Progreso y Salud.
Compartir en
 La fundación
La fundación
